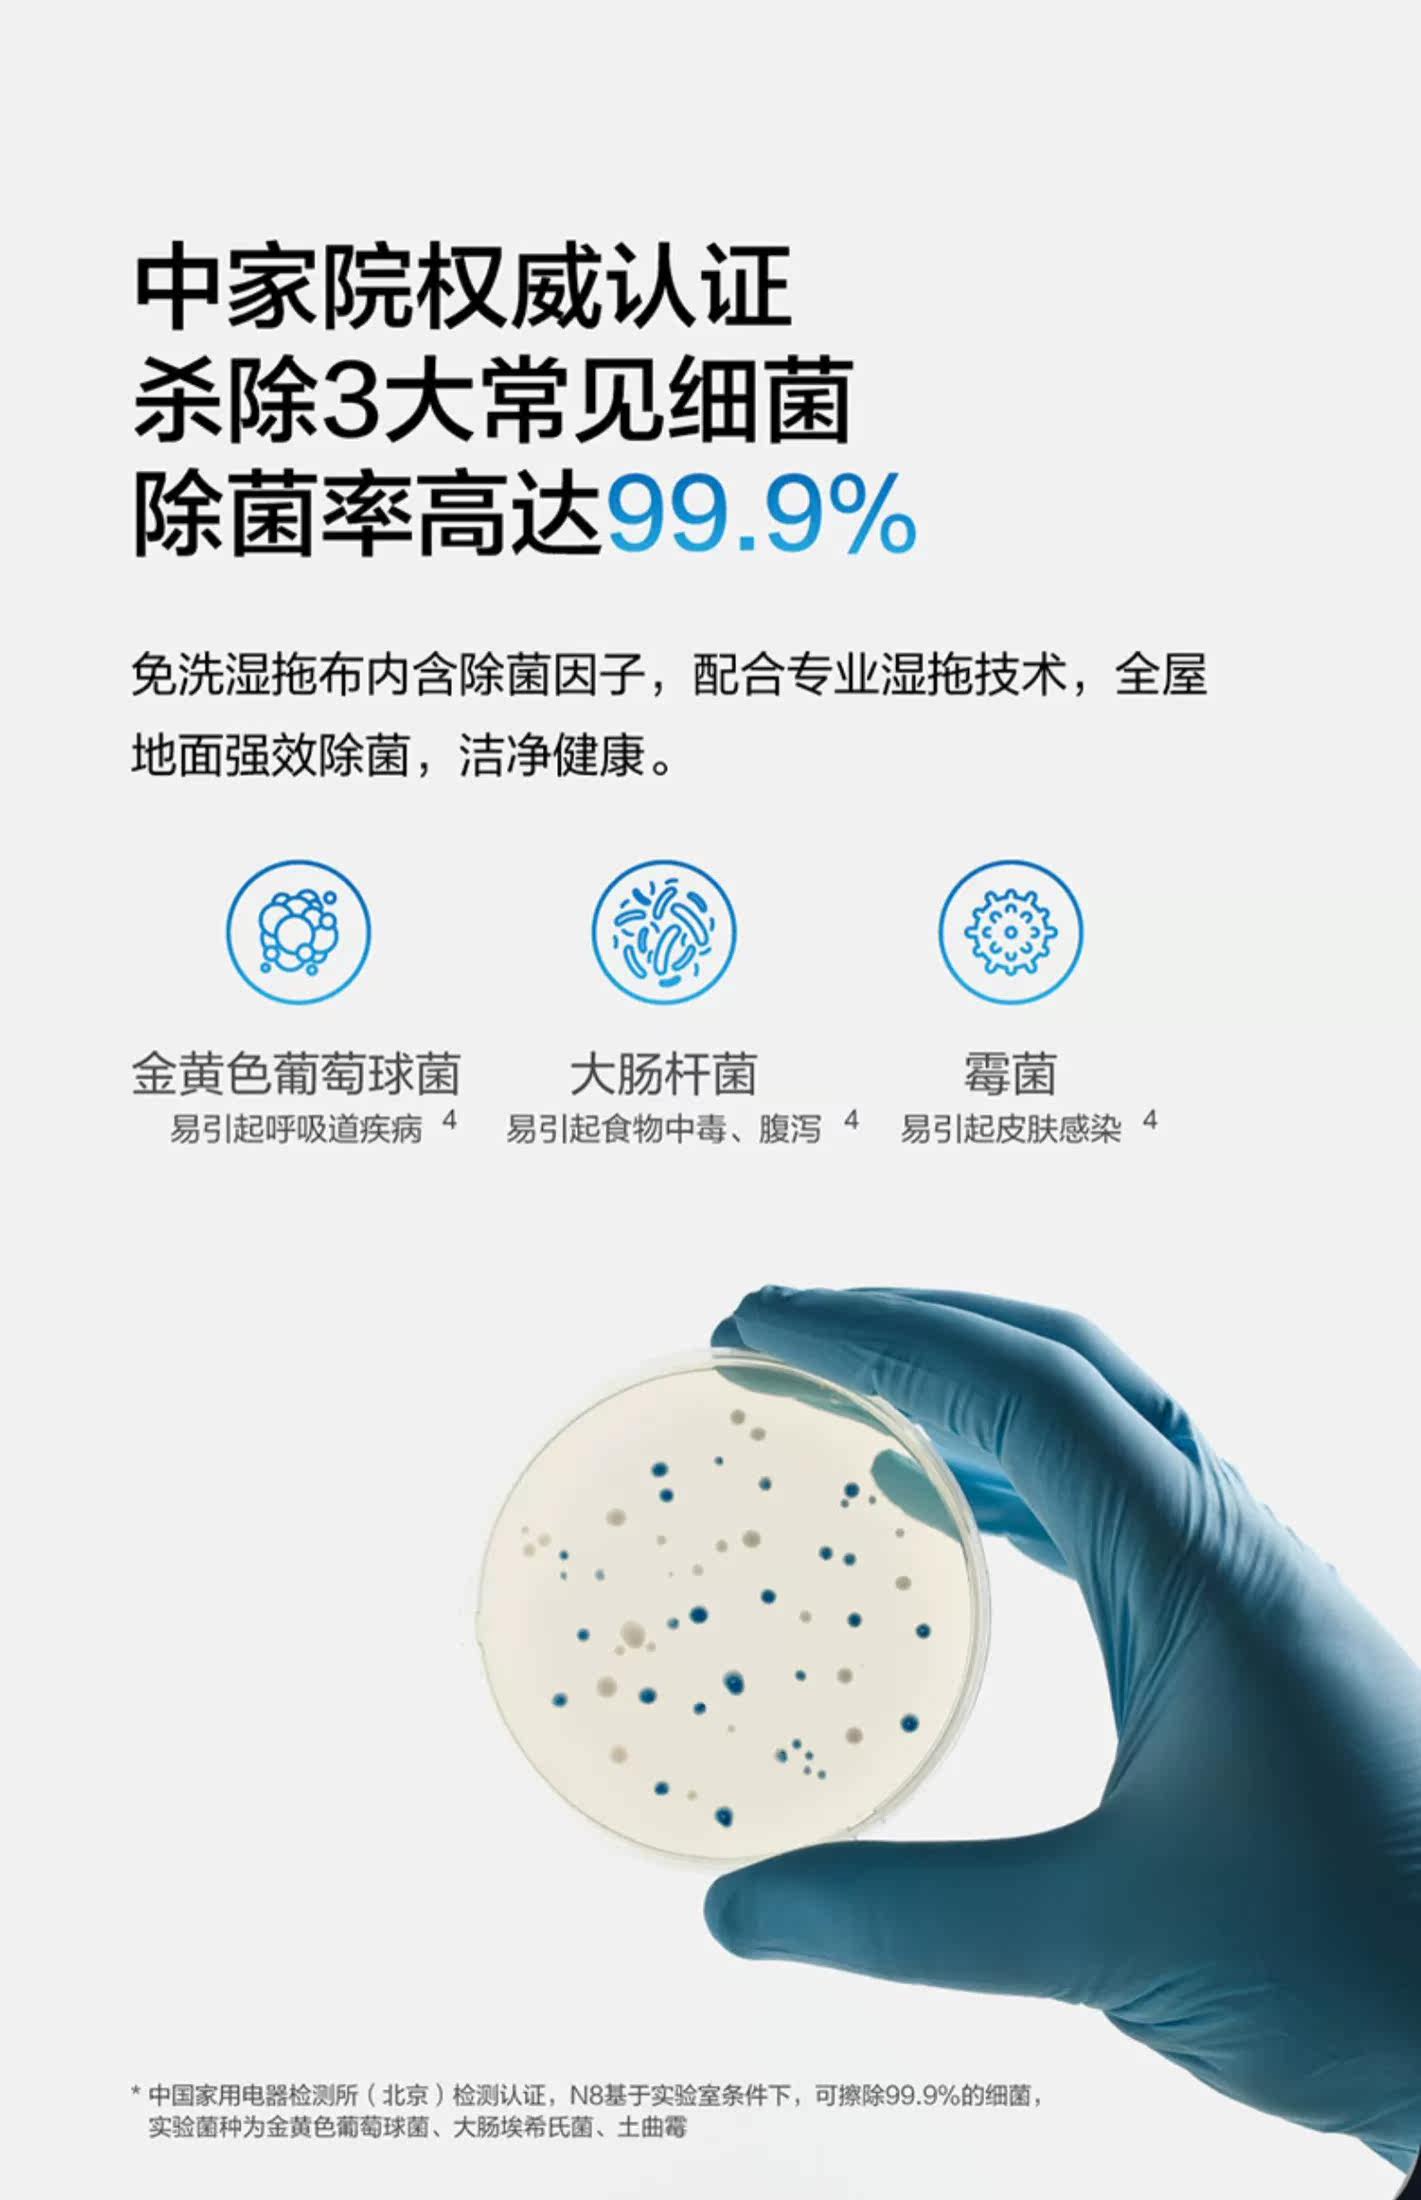

- Таобао
- Техника
- Бытовая техника
- Электрические щетки для уборки
- 633376727276
Cobos Diobao T5/N8 Широкий робот умный дом все -аутоматическое пылесос sweekeb

Цена: 47 889руб. (¥2299)
Артикул: 633376727276
Вес товара: ~0.7 кг. Указан усредненный вес, который может отличаться от фактического. Не включен в цену, оплачивается при получении.
Описание товараPHA+PGltZyBzcmM9Imh0dHBzOi8vaW1nLmFsaWNkbi5jb20vaW1nZXh0cmEvaTEvMTEyMDgzNjAwL08xQ04wMTdNbDJ2SjFjU3FUeTVlZW1sXyEhMTEyMDgzNjAwLmpwZyIgYWxpZ249ImFic21pZGRsZSI+PGltZyBzcmM9Imh0dHBzOi8vaW1nLmFsaWNkbi5jb20vaW1nZXh0cmEvaTQvMTEyMDgzNjAwL08xQ04wMUlTcWEyNDFjU3FUckRqdjl5XyEhMTEyMDgzNjAwLmpwZyIgYWxpZ249ImFic21pZGRsZSI+PGltZyBzcmM9Imh0dHBzOi8vaW1nLmFsaWNkbi5jb20vaW1nZXh0cmEvaTMvMTEyMDgzNjAwL08xQ04wMVV4NGtiMDFjU3FUdTVLWnY4XyEhMTEyMDgzNjAwLmpwZyIgYWxpZ249ImFic21pZGRsZSI+PGltZyBzcmM9Imh0dHBzOi8vaW1nLmFsaWNkbi5jb20vaW1nZXh0cmEvaTQvMTEyMDgzNjAwL08xQ04wMVlhcjd6ZDFjU3FUcDRJZmZmXyEhMTEyMDgzNjAwLmpwZyIgYWxpZ249ImFic21pZGRsZSI+PGltZyBzcmM9Imh0dHBzOi8vaW1nLmFsaWNkbi5jb20vaW1nZXh0cmEvaTMvMTEyMDgzNjAwL08xQ04wMTE3MkVYWjFjU3FUc29XS1FMXyEhMTEyMDgzNjAwLmpwZyIgYWxpZ249ImFic21pZGRsZSI+PGltZyBzcmM9Imh0dHBzOi8vaW1nLmFsaWNkbi5jb20vaW1nZXh0cmEvaTMvMTEyMDgzNjAwL08xQ04wMUhtVWtLMzFjU3FUa01HcHY2XyEhMTEyMDgzNjAwLmpwZyIgYWxpZ249ImFic21pZGRsZSI+PGltZyBzcmM9Imh0dHBzOi8vaW1nLmFsaWNkbi5jb20vaW1nZXh0cmEvaTMvMTEyMDgzNjAwL08xQ04wMVRFN2N0dDFjU3FUckRtUDFsXyEhMTEyMDgzNjAwLmpwZyIgYWxpZ249ImFic21pZGRsZSI+PGltZyBzcmM9Imh0dHBzOi8vaW1nLmFsaWNkbi5jb20vaW1nZXh0cmEvaTMvMTEyMDgzNjAwL08xQ04wMUJSbkhhTjFjU3FUZmRtSU9kXyEhMTEyMDgzNjAwLmpwZyIgYWxpZ249ImFic21pZGRsZSI+PGltZyBzcmM9Imh0dHBzOi8vaW1nLmFsaWNkbi5jb20vaW1nZXh0cmEvaTMvMTEyMDgzNjAwL08xQ04wMTJ2QTU0dTFjU3FUb0ViS1NUXyEhMTEyMDgzNjAwLmpwZyIgYWxpZ249ImFic21pZGRsZSI+PGltZyBzcmM9Imh0dHBzOi8vaW1nLmFsaWNkbi5jb20vaW1nZXh0cmEvaTIvMTEyMDgzNjAwL08xQ04wMTB1MEhoNDFjU3FUbzJmSVhmXyEhMTEyMDgzNjAwLmpwZyIgYWxpZ249ImFic21pZGRsZSI+PGltZyBzcmM9Imh0dHBzOi8vaW1nLmFsaWNkbi5jb20vaW1nZXh0cmEvaTEvMTEyMDgzNjAwL08xQ04wMUVPQlNydDFjU3FUc29YZmFnXyEhMTEyMDgzNjAwLmpwZyIgYWxpZ249ImFic21pZGRsZSI+PGltZyBzcmM9Imh0dHBzOi8vaW1nLmFsaWNkbi5jb20vaW1nZXh0cmEvaTMvMTEyMDgzNjAwL08xQ04wMWp6R0UyRDFjU3FUbzJiZzFBXyEhMTEyMDgzNjAwLmpwZyIgYWxpZ249ImFic21pZGRsZSI+PGltZyBzcmM9Imh0dHBzOi8vaW1nLmFsaWNkbi5jb20vaW1nZXh0cmEvaTIvMTEyMDgzNjAwL08xQ04wMWxSaHlDRTFjU3FUb0VZaUtxXyEhMTEyMDgzNjAwLmpwZyIgYWxpZ249ImFic21pZGRsZSI+PGltZyBzcmM9Imh0dHBzOi8vaW1nLmFsaWNkbi5jb20vaW1nZXh0cmEvaTEvMTEyMDgzNjAwL08xQ04wMTlCanVHSTFjU3FUbm5RdktKXyEhMTEyMDgzNjAwLmpwZyIgYWxpZ249ImFic21pZGRsZSI+PGltZyBzcmM9Imh0dHBzOi8vaW1nLmFsaWNkbi5jb20vaW1nZXh0cmEvaTEvMTEyMDgzNjAwL08xQ04wMU1TR3JRaDFjU3FUcThuU3A4XyEhMTEyMDgzNjAwLmpwZyIgYWxpZ249ImFic21pZGRsZSI+PGltZyBzcmM9Imh0dHBzOi8vaW1nLmFsaWNkbi5jb20vaW1nZXh0cmEvaTMvMTEyMDgzNjAwL08xQ04wMUk5OVgyWDFjU3FUczl3S0h6XyEhMTEyMDgzNjAwLmpwZyIgYWxpZ249ImFic21pZGRsZSI+PGltZyBzcmM9Imh0dHBzOi8vaW1nLmFsaWNkbi5jb20vaW1nZXh0cmEvaTMvMTEyMDgzNjAwL08xQ04wMVhaSWRiRDFjU3FUczl1Rk5LXyEhMTEyMDgzNjAwLmpwZyIgYWxpZ249ImFic21pZGRsZSI+PGltZyBzcmM9Imh0dHBzOi8vaW1nLmFsaWNkbi5jb20vaW1nZXh0cmEvaTMvMTEyMDgzNjAwL08xQ04wMUt0MnFCZTFjU3FUb0VacjEzXyEhMTEyMDgzNjAwLmpwZyIgYWxpZ249ImFic21pZGRsZSI+PGltZyBzcmM9Imh0dHBzOi8vaW1nLmFsaWNkbi5jb20vaW1nZXh0cmEvaTIvMTEyMDgzNjAwL08xQ04wMVhtTUtxUDFjU3FUdGhWOTUzXyEhMTEyMDgzNjAwLmpwZyIgYWxpZ249ImFic21pZGRsZSI+PGltZyBzcmM9Imh0dHBzOi8vaW1nLmFsaWNkbi5jb20vaW1nZXh0cmEvaTMvMTEyMDgzNjAwL08xQ04wMUlMMkY1bTFjU3FUbFhrdWZzXyEhMTEyMDgzNjAwLmpwZyIgYWxpZ249ImFic21pZGRsZSI+PGltZyBzcmM9Imh0dHBzOi8vaW1nLmFsaWNkbi5jb20vaW1nZXh0cmEvaTIvMTEyMDgzNjAwL08xQ04wMUc5NVRiNjFjU3FUbzJmSVp4XyEhMTEyMDgzNjAwLmpwZyIgYWxpZ249ImFic21pZGRsZSI+PGltZyBzcmM9Imh0dHBzOi8vaW1nLmFsaWNkbi5jb20vaW1nZXh0cmEvaTMvMTEyMDgzNjAwL08xQ04wMVNHcm5vdTFjU3FUcThvYlljXyEhMTEyMDgzNjAwLmpwZyIgYWxpZ249ImFic21pZGRsZSI+PGltZyBzcmM9Imh0dHBzOi8vaW1nLmFsaWNkbi5jb20vaW1nZXh0cmEvaTEvMTEyMDgzNjAwL08xQ04wMVlFRDJPcTFjU3FUb0ViU3A0XyEhMTEyMDgzNjAwLmpwZyIgYWxpZ249ImFic21pZGRsZSI+PGltZyBzcmM9Imh0dHBzOi8vaW1nLmFsaWNkbi5jb20vaW1nZXh0cmEvaTMvMTEyMDgzNjAwL08xQ04wMUVMcnZsYTFjU3FUbm5PMllvXyEhMTEyMDgzNjAwLmpwZyIgYWxpZ249ImFic21pZGRsZSI+PGltZyBzcmM9Imh0dHBzOi8vaW1nLmFsaWNkbi5jb20vaW1nZXh0cmEvaTIvMTEyMDgzNjAwL08xQ04wMTZJcmxLTDFjU3FUZmRtTWMyXyEhMTEyMDgzNjAwLmpwZyIgYWxpZ249ImFic21pZGRsZSI+PGltZyBzcmM9Imh0dHBzOi8vaW1nLmFsaWNkbi5jb20vaW1nZXh0cmEvaTEvMTEyMDgzNjAwL08xQ04wMVlYYnIyNTFjU3FUb0VjUDNLXyEhMTEyMDgzNjAwLmpwZyIgYWxpZ249ImFic21pZGRsZSI+PGltZyBzcmM9Imh0dHBzOi8vaW1nLmFsaWNkbi5jb20vaW1nZXh0cmEvaTQvMTEyMDgzNjAwL08xQ04wMThGV2U2VjFjU3FUbzJlMWJJXyEhMTEyMDgzNjAwLmpwZyIgYWxpZ249ImFic21pZGRsZSI+PGltZyBzcmM9Imh0dHBzOi8vaW1nLmFsaWNkbi5jb20vaW1nZXh0cmEvaTMvMTEyMDgzNjAwL08xQ04wMTdmUk5JbzFjU3FUb0VacjQ0XyEhMTEyMDgzNjAwLmpwZyIgYWxpZ249ImFic21pZGRsZSI+PGltZyBzcmM9Imh0dHBzOi8vaW1nLmFsaWNkbi5jb20vaW1nZXh0cmEvaTEvMTEyMDgzNjAwL08xQ04wMTlnUm1pRzFjU3FUc29aTGF4XyEhMTEyMDgzNjAwLmpwZyIgYWxpZ249ImFic21pZGRsZSI+PGltZyBzcmM9Imh0dHBzOi8vaW1nLmFsaWNkbi5jb20vaW1nZXh0cmEvaTQvMTEyMDgzNjAwL08xQ04wMVJpTWo4NTFjU3FUb0VhQnJzXyEhMTEyMDgzNjAwLmpwZyIgYWxpZ249ImFic21pZGRsZSI+PGltZyBzcmM9Imh0dHBzOi8vaW1nLmFsaWNkbi5jb20vaW1nZXh0cmEvaTIvMTEyMDgzNjAwL08xQ04wMWpSM2syaDFjU3FUbFhpeThLXyEhMTEyMDgzNjAwLmpwZyIgYWxpZ249ImFic21pZGRsZSI+PGltZyBzcmM9Imh0dHBzOi8vaW1nLmFsaWNkbi5jb20vaW1nZXh0cmEvaTMvMTEyMDgzNjAwL08xQ04wMWIybldvNzFjU3FUbTJ2TmpJXyEhMTEyMDgzNjAwLmpwZyIgYWxpZ249ImFic21pZGRsZSI+PGltZyBzcmM9Imh0dHBzOi8vaW1nLmFsaWNkbi5jb20vaW1nZXh0cmEvaTQvMTEyMDgzNjAwL08xQ04wMWF2enh5TjFjU3FUcDROUjBsXyEhMTEyMDgzNjAwLmpwZyIgYWxpZ249ImFic21pZGRsZSI+PGltZyBzcmM9Imh0dHBzOi8vaW1nLmFsaWNkbi5jb20vaW1nZXh0cmEvaTMvMTEyMDgzNjAwL08xQ04wMWZmTjhITjFjU3FUcXJCdVFFXyEhMTEyMDgzNjAwLmpwZyIgYWxpZ249ImFic21pZGRsZSI+PGltZyBzcmM9Imh0dHBzOi8vaW1nLmFsaWNkbi5jb20vaW1nZXh0cmEvaTMvMTEyMDgzNjAwL08xQ04wMTgyMVlOdDFjU3FUc29ZVGE0XyEhMTEyMDgzNjAwLmpwZyIgYWxpZ249ImFic21pZGRsZSI+PGltZyBzcmM9Imh0dHBzOi8vaW1nLmFsaWNkbi5jb20vaW1nZXh0cmEvaTEvMTEyMDgzNjAwL08xQ04wMXdYNGJOMjFjU3FUc29aUG0xXyEhMTEyMDgzNjAwLmpwZyIgYWxpZ249ImFic21pZGRsZSI+PGltZyBzcmM9Imh0dHBzOi8vaW1nLmFsaWNkbi5jb20vaW1nZXh0cmEvaTMvMTEyMDgzNjAwL08xQ04wMW93RWVzaDFjU3FUbzJmQUxNXyEhMTEyMDgzNjAwLmpwZyIgYWxpZ249ImFic21pZGRsZSI+PC9wPg==
Продавец:世纪百诚家电官方旗舰店
Адрес:Гуандун
Рейтинг:

Всего отзывов:186512
Положительных:186512
Выберите вариацию / цвет
Добавить в корзину
- Информация о товаре
- Фотографии